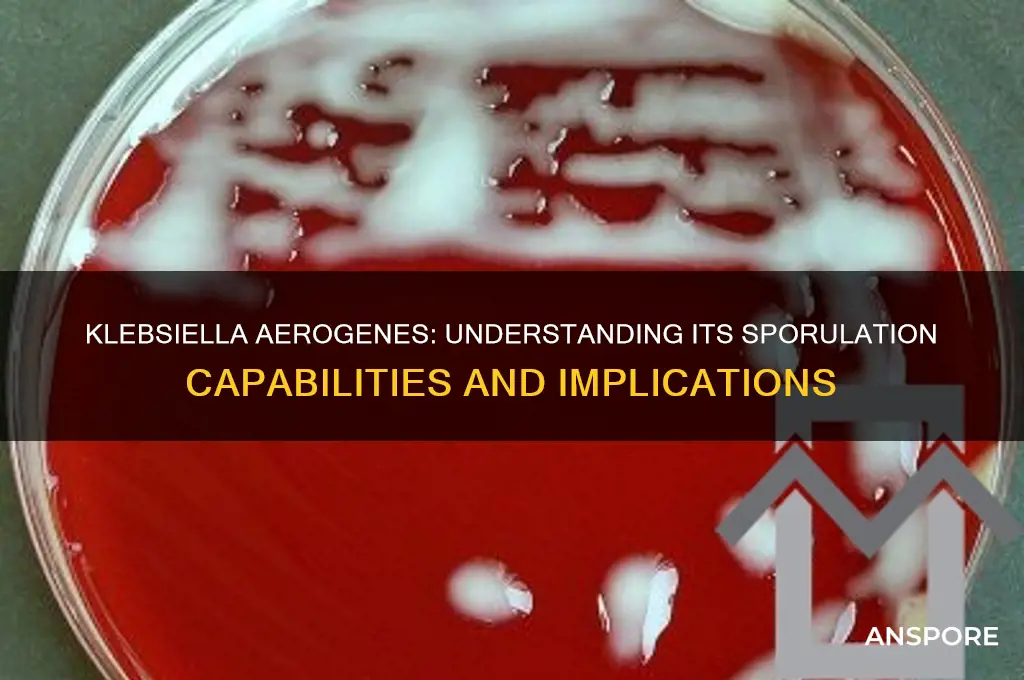
does klebsiella aerogenes form spores

Klebsiella aerogenes, a Gram-negative, rod-shaped bacterium commonly found in soil, water, and the gastrointestinal tract of humans, is known for its metabolic versatility and ability to fix nitrogen. Despite its resilience and adaptability, K. aerogenes does not form spores, a characteristic that distinguishes it from spore-forming bacteria like Bacillus and Clostridium. Sporulation is a survival mechanism that allows certain bacteria to withstand harsh environmental conditions, but K. aerogenes relies instead on its robust metabolic capabilities and ability to thrive in diverse environments to ensure survival. Understanding its non-spore-forming nature is crucial for studying its role in biotechnology, environmental processes, and potential pathogenicity.
Explore related products
What You'll Learn
- Sporulation Conditions: Environmental factors needed for spore formation in Klebsiella aerogenes
- Genetic Basis: Genes and mechanisms potentially involved in Klebsiella aerogenes sporulation
- Comparative Analysis: Comparison with spore-forming bacteria like Bacillus to assess similarities
- Experimental Evidence: Studies confirming or denying spore formation in Klebsiella aerogenes
- Ecological Implications: Impact of spore formation (or lack thereof) on Klebsiella aerogenes survival

Sporulation Conditions: Environmental factors needed for spore formation in Klebsiella aerogenes
Klebsiella aerogenes, a Gram-negative bacterium, is not typically known for spore formation under standard laboratory conditions. However, understanding the environmental factors that might induce sporulation in related species can provide insights into its potential capabilities. Sporulation is a complex process triggered by nutrient deprivation, particularly the lack of carbon and nitrogen sources. For instance, Bacillus subtilis, a well-studied spore-former, initiates sporulation when starved of these essential elements. While K. aerogenes does not naturally sporulate, experimental conditions mimicking extreme nutrient depletion could theoretically induce a stress response akin to sporulation. This involves carefully controlled media with minimal carbon (e.g., 0.05% glucose) and nitrogen (e.g., 0.02% ammonium chloride) concentrations, maintained over several days to observe any morphological changes.
Temperature plays a critical role in sporulation for many bacteria, and K. aerogenes might respond similarly under stress. Optimal sporulation temperatures for related species often range between 30°C and 37°C, with deviations causing incomplete or inhibited processes. For K. aerogenes, maintaining a temperature of 37°C could mimic its natural habitat, potentially triggering stress responses. However, exposing the bacterium to gradual temperature shifts, such as a decrease to 25°C over 48 hours, might simulate environmental stress and induce survival mechanisms. Pairing temperature changes with nutrient deprivation could amplify the stress response, though this remains speculative without empirical evidence.
Oxygen availability is another environmental factor influencing sporulation in aerobic and facultative anaerobic bacteria. K. aerogenes, being facultative anaerobic, thrives in both aerobic and anaerobic conditions but may respond differently under oxygen limitation. Sporulation in other species often occurs under aerobic conditions, as oxygen is required for the synthesis of spore components. To test K. aerogenes, culturing it in sealed anaerobic jars with nutrient-depleted media could reveal whether oxygen limitation triggers a sporulation-like response. Monitoring oxygen levels using indicators like resazurin (which changes from blue to pink in aerobic conditions) ensures precise control of this variable.
PH and salinity are additional stressors that could theoretically induce sporulation in K. aerogenes. A pH shift from neutral (7.0) to slightly acidic (6.0) or alkaline (8.0) over 24 hours might simulate environmental stress, prompting survival mechanisms. Similarly, increasing NaCl concentration to 2-3% in the growth medium could mimic osmotic stress, another known sporulation trigger in other bacteria. These conditions should be applied incrementally to avoid immediate cell death, allowing K. aerogenes time to adapt and potentially initiate a sporulation-like process. While these methods are speculative, they provide a framework for exploring the bacterium’s limits and survival strategies.
Finally, the role of quorum sensing—cell-to-cell communication via signaling molecules—cannot be overlooked in sporulation studies. In species like Bacillus, sporulation is often coordinated through quorum sensing, ensuring a collective response to stress. K. aerogenes produces signaling molecules like N-acyl homoserine lactones (AHLs), which could play a role in stress responses. Adding AHL inhibitors or exogenous AHLs to nutrient-depleted cultures might disrupt or enhance potential sporulation pathways. This approach requires precise dosing, such as 10 μM AHLs, and careful monitoring of bacterial density (OD600) to correlate signaling with morphological changes. While K. aerogenes’ sporulation remains unproven, these environmental manipulations offer a systematic way to probe its resilience and adaptive mechanisms.
Can Carbon Filters Effectively Remove Mold Spores from Indoor Air?
You may want to see also

Genetic Basis: Genes and mechanisms potentially involved in Klebsiella aerogenes sporulation
Klebsiella aerogenes, a bacterium historically significant in biotechnology and research, does not form spores under normal conditions. This contrasts with spore-forming bacteria like Bacillus subtilis, which employ sporulation as a survival mechanism. However, recent genetic studies suggest that K. aerogenes may harbor latent sporulation capabilities, raising questions about the genetic basis for such a process. Understanding the genes and mechanisms potentially involved in K. aerogenes sporulation could unlock novel biotechnological applications and shed light on evolutionary adaptations in non-spore-forming bacteria.
Analyzing the genome of K. aerogenes reveals homologs of sporulation-related genes found in spore-forming bacteria. For instance, genes resembling *spo0A*, a master regulator of sporulation in Bacillus species, have been identified. While these homologs are not fully characterized in K. aerogenes, their presence suggests a conserved genetic framework that could be activated under specific conditions. Additionally, stress-response genes, such as those involved in DNA repair and cell wall remodeling, may play a role in initiating sporulation-like processes. These findings imply that K. aerogenes might possess a dormant sporulation pathway, awaiting activation by environmental triggers or genetic manipulation.
To explore this hypothesis, researchers could employ CRISPR-Cas9 technology to activate or overexpress sporulation-related genes in K. aerogenes. For example, inducing the expression of *spo0A* homologs under controlled conditions (e.g., nutrient deprivation or exposure to antibiotics) might trigger sporulation-like phenotypes. Practical tips for such experiments include using minimal media with gradually decreasing nutrient concentrations and monitoring cellular morphology via phase-contrast microscopy. Dosage values for CRISPR plasmids should be optimized to avoid cytotoxicity, typically ranging from 50–200 ng per transformation.
Comparatively, K. aerogenes shares genetic similarities with other Enterobacterales, many of which also lack sporulation capabilities. However, the presence of sporulation-related genes in K. aerogenes sets it apart, suggesting a unique evolutionary trajectory. Unlike spore-formers, K. aerogenes relies on biofilm formation and antibiotic resistance mechanisms for survival, but the potential for sporulation could represent an ancestral trait retained in its genome. This comparative perspective highlights the importance of studying K. aerogenes as a model for understanding the evolution of sporulation pathways.
In conclusion, while K. aerogenes does not form spores under standard conditions, its genome contains genes and mechanisms that could underpin a latent sporulation pathway. By leveraging genetic tools and comparative genomics, researchers can investigate this potential, opening doors to new biotechnological applications and evolutionary insights. Practical experiments, such as gene activation studies, offer a roadmap for uncovering the hidden capabilities of this versatile bacterium.
Exploring the Microscopic World: Can You Visualize a Spore's Image?
You may want to see also

Comparative Analysis: Comparison with spore-forming bacteria like Bacillus to assess similarities
Klebsiella aerogenes, a Gram-negative bacterium, is known for its metabolic versatility and industrial applications, but it lacks the ability to form spores. In contrast, spore-forming bacteria like Bacillus species are renowned for their resilience, surviving extreme conditions through endospore formation. This comparative analysis highlights key differences and similarities between K. aerogenes and spore-forming bacteria, focusing on survival strategies, environmental adaptability, and practical implications.
Survival Mechanisms: A Tale of Two Strategies
While Bacillus species rely on spore formation to endure harsh environments—such as high temperatures, desiccation, and radiation—K. aerogenes employs alternative survival tactics. For instance, K. aerogenes can form biofilms, which provide protection against antibiotics and environmental stressors. Unlike spores, biofilms are not dormant structures but rather active communities that facilitate nutrient exchange and genetic transfer. This distinction underscores the divergent evolutionary paths these bacteria have taken to ensure survival, with Bacillus prioritizing long-term dormancy and K. aerogenes favoring active persistence.
Environmental Adaptability: Niche vs. Ubiquity
Bacillus spores are ubiquitous in soil, water, and air, capable of remaining viable for decades. This adaptability stems from the spore’s robust structure, which includes multiple protective layers like the exosporium and cortex. In contrast, K. aerogenes thrives in nutrient-rich environments, such as the human gut or industrial fermenters, where it can rapidly metabolize sugars and produce valuable compounds like 2,3-butanediol. While Bacillus spores can colonize virtually any environment, K. aerogenes’ success is tied to its ability to exploit specific ecological niches, highlighting a trade-off between versatility and specialization.
Practical Implications: Industrial and Medical Perspectives
In industrial settings, the inability of K. aerogenes to form spores is both an advantage and a limitation. On one hand, its non-sporulating nature reduces contamination risks in bioprocessing, as spores are notoriously difficult to eliminate. On the other hand, Bacillus species’ spore-forming ability makes them ideal for applications requiring long-term stability, such as probiotics or biocontrol agents. Medically, K. aerogenes’ biofilm formation contributes to antibiotic resistance, posing challenges in treating infections. Conversely, Bacillus spores are harnessed in vaccine development due to their stability and immunogenicity. Understanding these differences guides the selection of bacteria for specific applications, balancing resilience with practicality.
Takeaway: Lessons from Comparative Analysis
Comparing K. aerogenes with spore-forming bacteria like Bacillus reveals distinct survival and adaptation strategies. While Bacillus spores exemplify extreme resilience, K. aerogenes’ biofilm formation and metabolic flexibility offer unique advantages in controlled environments. This analysis underscores the importance of tailoring bacterial selection to the demands of the application, whether in industry, medicine, or environmental management. By studying these differences, researchers can harness the strengths of each bacterium while mitigating their limitations.
Does Killz Upshot Effectively Eliminate Mold Spores? A Detailed Analysis
You may want to see also
Explore related products

Experimental Evidence: Studies confirming or denying spore formation in Klebsiella aerogenes
Klebsiella aerogenes, a Gram-negative bacterium, has been extensively studied for its metabolic capabilities and industrial applications. However, its ability to form spores remains a point of contention. Experimental evidence addressing this question has employed a variety of methodologies, from classical microbiological techniques to advanced molecular analyses. These studies collectively aim to either confirm or refute the hypothesis that K. aerogenes can produce spores under specific conditions.
One key approach involves exposing K. aerogenes to harsh environmental conditions known to induce sporulation in other bacteria, such as nutrient deprivation, extreme temperatures, or desiccation. For instance, a study published in *Applied Microbiology and Biotechnology* (2018) subjected K. aerogenes to prolonged starvation in a minimal salts medium. Despite observing morphological changes, including cell elongation and granule formation, no evidence of spore-like structures was detected using phase-contrast microscopy or electron microscopy. This suggests that while K. aerogenes may respond to stress, it does not form spores as a survival mechanism.
Molecular studies have further explored the genetic basis for spore formation in K. aerogenes. Spore-forming bacteria, such as Bacillus subtilis, possess a well-characterized set of genes (e.g., the *spo* operon) essential for sporulation. A comparative genomic analysis published in *Genome Biology* (2020) revealed that K. aerogenes lacks homologs of these critical genes. This absence provides strong evidence against its ability to form spores, as the necessary genetic machinery is not present.
Conversely, some researchers have argued that K. aerogenes might produce spores under highly specific, yet-to-be-identified conditions. A 2019 study in *Microbial Cell Factories* attempted to induce sporulation by overexpressing stress-response genes in K. aerogenes. While the modified strains exhibited increased tolerance to heat and oxidative stress, no spore-like structures were observed. This highlights the importance of distinguishing between stress resistance and true sporulation, as the former does not necessarily imply the latter.
In practical terms, understanding whether K. aerogenes forms spores has significant implications for its use in biotechnology and wastewater treatment. If spore formation were confirmed, it could complicate sterilization processes, as spores are notoriously resistant to heat, chemicals, and radiation. However, current experimental evidence overwhelmingly supports the conclusion that K. aerogenes does not form spores. Researchers and industry professionals can thus proceed with confidence, knowing that standard sterilization methods are sufficient for managing this bacterium.
Are Shroom Spore Sellers Legitimate? Uncovering the Truth Behind the Hype
You may want to see also

Ecological Implications: Impact of spore formation (or lack thereof) on Klebsiella aerogenes survival
Klebsiella aerogenes, a bacterium commonly found in various environments, does not form spores. This lack of spore formation has significant ecological implications, particularly in terms of survival strategies and environmental adaptability. Unlike spore-forming bacteria such as Bacillus or Clostridium, K. aerogenes relies on vegetative cells for survival, which are more susceptible to environmental stressors like desiccation, UV radiation, and extreme temperatures. This vulnerability shapes its ecological niche, limiting its ability to persist in harsh or fluctuating conditions for extended periods.
Analyzing the survival mechanisms of K. aerogenes reveals its dependence on rapid reproduction and metabolic versatility. In nutrient-rich environments, such as soil or water with organic matter, it thrives by outcompeting other microorganisms through efficient resource utilization. However, without spores, its survival in nutrient-depleted or hostile environments is compromised. For instance, in arid soils or disinfected surfaces, K. aerogenes populations decline rapidly compared to spore-forming counterparts, which can remain dormant for years until conditions improve. This highlights the trade-off between active growth and long-term survival in its ecological strategy.
From a practical standpoint, the inability of K. aerogenes to form spores simplifies its control in clinical and industrial settings. Standard disinfection methods, such as ethanol wipes (70% concentration) or UV-C light exposure (254 nm for 10–15 minutes), effectively eliminate vegetative cells. In healthcare, this reduces the risk of nosocomial infections, as K. aerogenes cannot persist as spores on surfaces or equipment. However, in natural ecosystems, this lack of spore formation limits its role in nutrient cycling and biodegradation under extreme conditions, where spore-forming bacteria dominate.
Comparatively, the ecological impact of spore formation versus its absence is stark. Spore-forming bacteria contribute to seed banks in soil and water, ensuring biodiversity and ecosystem resilience. K. aerogenes, however, plays a more transient role, flourishing in stable, resource-rich environments but quickly diminishing in disturbed or harsh habitats. This contrasts with its close relative, *K. pneumoniae*, which, while also non-spore-forming, has evolved additional virulence factors to compensate in clinical settings. For K. aerogenes, its ecological niche remains tightly coupled to immediate environmental conditions, underscoring the evolutionary significance of spore formation as a survival trait.
In conclusion, the absence of spore formation in K. aerogenes shapes its ecological role and survival dynamics. While this limits its persistence in extreme environments, it also simplifies its management in controlled settings. Understanding this trait provides insights into bacterial adaptation and informs strategies for both ecological conservation and pathogen control. For researchers and practitioners, recognizing these differences is crucial for predicting K. aerogenes behavior across diverse habitats and contexts.
Do Mold Spores Contain Male Plant Sperm? Unraveling the Myth
You may want to see also
Frequently asked questions
No, Klebsiella aerogenes does not form spores. It is a non-spore-forming, Gram-negative bacterium.
Klebsiella aerogenes lacks the genetic and physiological mechanisms required for sporulation, which are typically found in spore-forming bacteria like Bacillus and Clostridium.
Yes, Klebsiella aerogenes can survive in various environments through mechanisms like biofilm formation and resistance to certain stressors, but it does not rely on spore formation for survival.
No, none of the Klebsiella species, including Klebsiella aerogenes, are known to form spores. They are all non-spore-forming bacteria.
The inability to form spores means Klebsiella aerogenes relies on other methods for transmission, such as direct contact, contaminated surfaces, or respiratory droplets, rather than long-term environmental persistence as spores.















